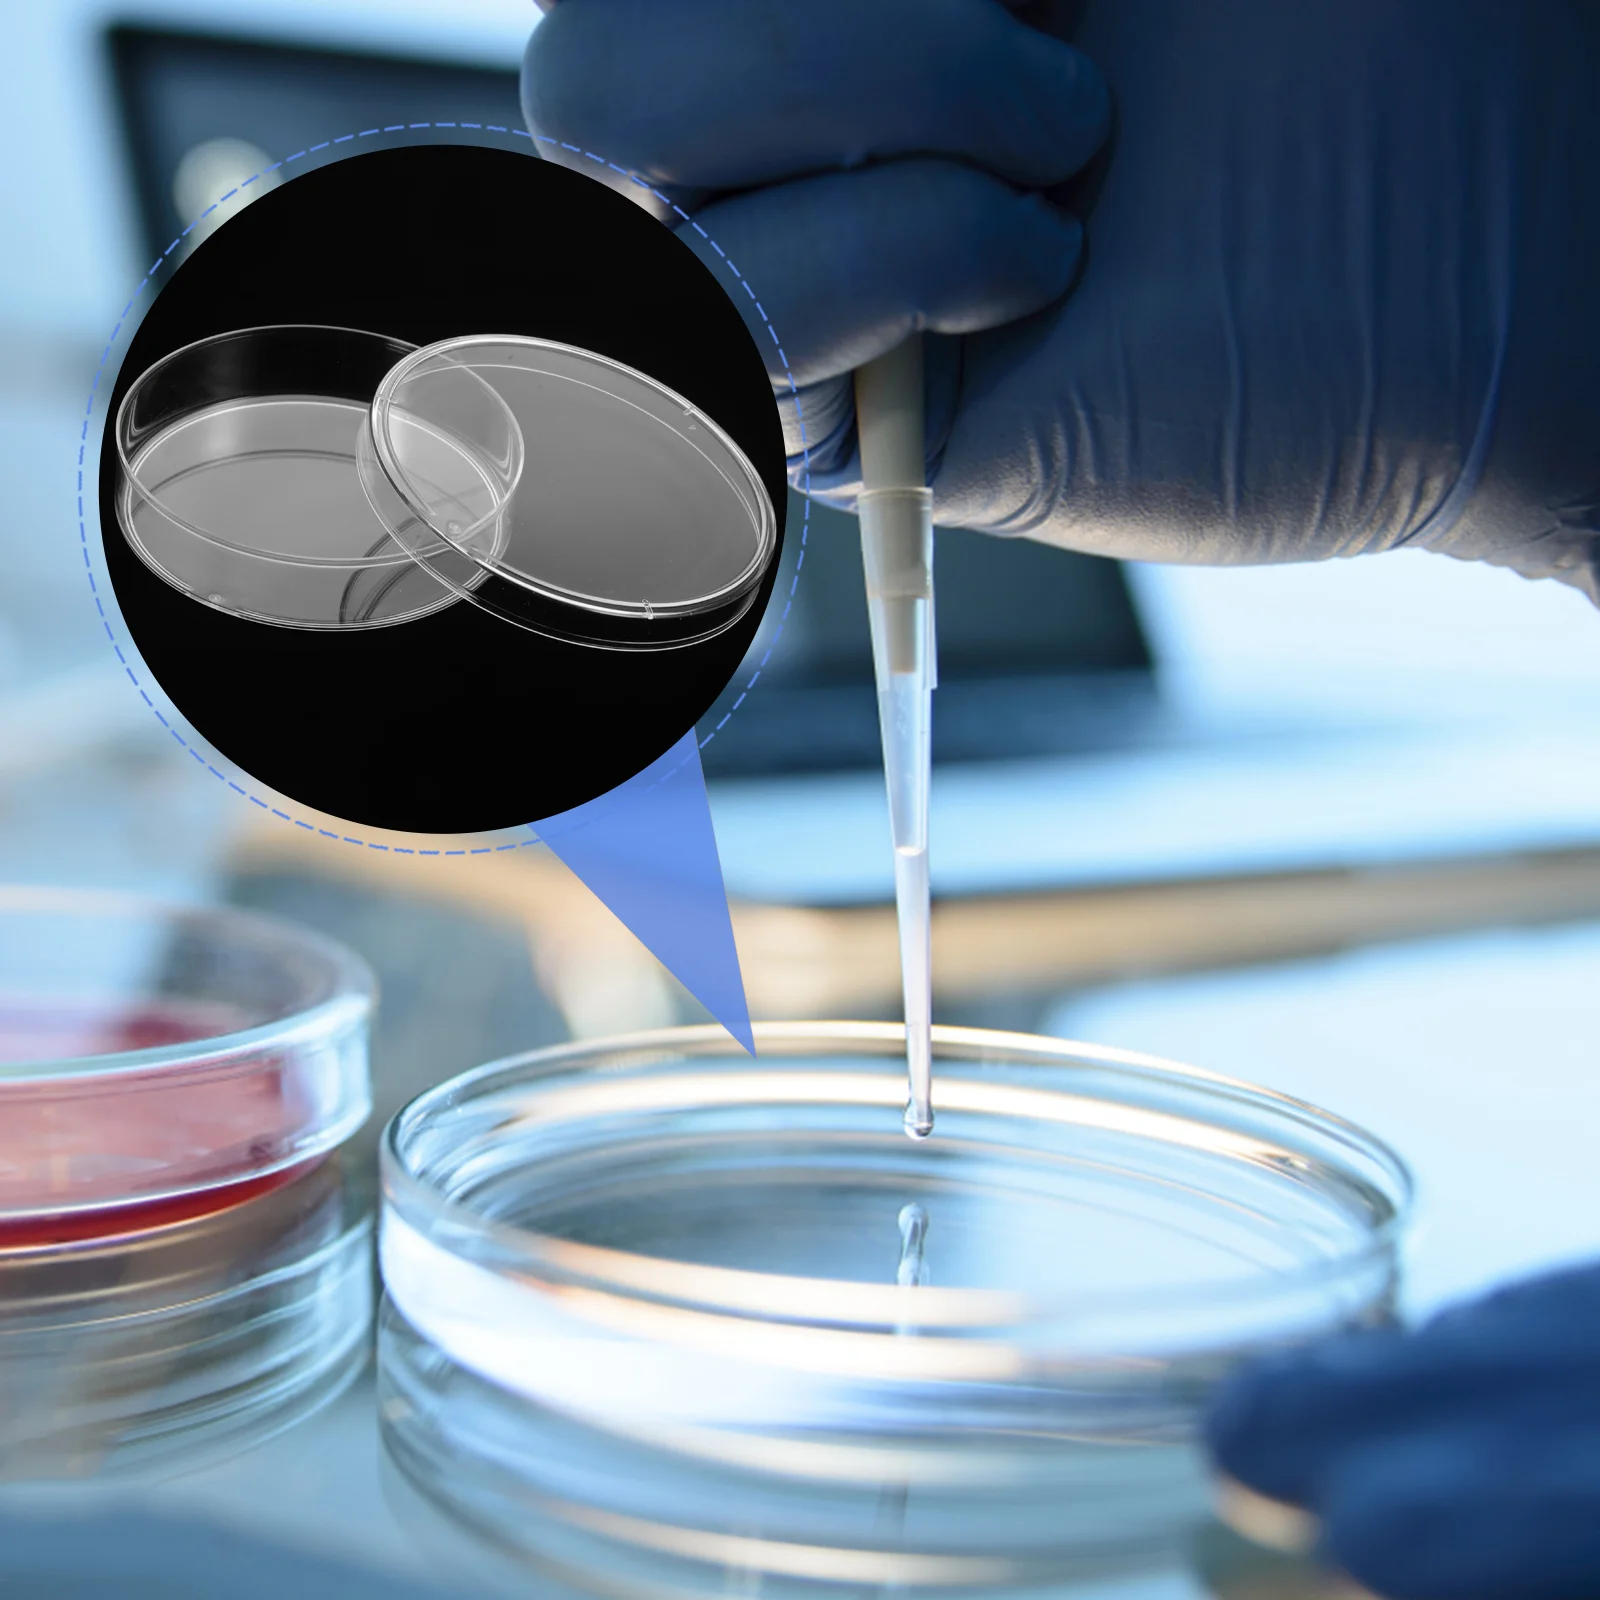
10 Pcs Square Petri Dish Mushroom Agar Plates Round Culture Plastic Chemistry Holder Science Supplies Dishes

Женский свитшот с флисовой подкладкой ENjoyce, теплый Свободный пуловер составного кроя, толстый свитшот в Корейском стиле, для занятий спортом, для улицы, для зимы, 2023
Price history chart & currency exchange rate
Customers also viewed

$4.42
1pc Diamond Grinding Wheel Dresser Thickening Grinding Layer Metal Grinder Stone Grinding Dressing Tool
aliexpress.com
$10.50
Crystal Full Square AB Diy Diamond Painting Cross Stitch Cats Animals Embroidery Santa Claus Mosaic Home Decor Rhinestones Gift
aliexpress.ru
$34.00
Новые оригинальные аксессуары для топливного инжектора CFMOTO 250CLX, топливный инжектор CLX250, масляная Зажигалка 300SR
aliexpress.ru
$33.38
DIY Book Nook Kit Подставка для книг Книжная полка Вставка 3D-головоломка Декоративная подставка для книг со светодиодной подсветкой DIY Подставка для книг Конструктор Модель Комплект для
aliexpress.ru
$55.92
Новый скутер 48V100Ah 1000w 13S3P XT60 48V комплект литий-ионный батарей 100000mah для электровелосипеда 54,6 v электрический велосипед скутер с BMS + зарядное устройство
aliexpress.ru
$53.99
Ультразвуковой дефектоскоп Φ 10F5, 5 МГц, двойной кристаллический прямой зонд, неразрушающий тестер, сфокусированный зонд 2,5 P
aliexpress.ru
$1.96
Съемные фотообои съемные обертки вышивка искусственный воротник кукла искусственный воротник Мини-накидка Женская шаль
aliexpress.ru
$0.32
20 шт. зажимы для крепления порога двери фиксированный Фиксатор с заклепками для BMW E30 E36 51471840961 держатель заклепки порогового крепления
aliexpress.ru
$65.99
Elegant Dark Brunt Orange Long Prom Gown Sweetheart Satin Pleat Floor-Length Sleeveless Side Slit Formal Event Evening Dress
aliexpress.com
$0.73
1pcs Swivel Head Vacuum Cleaner Nozzle Rotating Head For Truck-mounted Vacuums Carpet Cleaning Systems For B203665y Pipe Fitting
aliexpress.com
$20.14
Portable Three Folding Keypanel with Touchpad Left Right Button Travel Keyboard for Win iOS Android Tablet PC Computers
aliexpress.com
$87.45
Рюкзак Fjallraven Kanken Rainbow цвет красный большой с аппликацией F23620.326.907-326
answear.ua
$18.20
Sea Shells Hoodies Female Long-Sleeve Reef Madness Elegant Casual Hoodie Hot Winter Street Fashion Oversize Graphic Sweatshirts
aliexpress.com
$4.90
20pcs Artificial Silk Marigold Flower Head For Wed Home Decor Birthday Party Supplies Accessories DIY Garden Vases Fake Flowers
aliexpress.com
$2.69
10 Pcs Square Petri Dish Mushroom Agar Plates Round Culture Plastic Chemistry Holder Science Supplies Dishes
aliexpress.com
$11.52
TF-карта Micro SD гибкий удлинитель кабеля адаптер удлинитель молния удлинитель кабеля карта памяти УДЛИНИТЕЛЬ шнур линейка FPC
aliexpress.ru
$87.60
High Pressure Dual-display Digital Manual T-shirt Heat Press Machine EU Plug 230V Power Tool
aliexpress.com
$12.34
Heelys 2020 New USB Charge LED Colorful Children with Two Wheels Roller Skate Shoes Boys Girls Shoes Kids Sneakers Blue Orange
aliexpress.com
$2.27
Aquarium Clean Siphon Vacuum Water Change Gravel Cleaner Fish Tank Pump Filter Dropshipping
aliexpress.com
$33.02
Осенне-зимняя женская симпатичная шапка-пуловер из флиса, теплая, вязаная шапка-ушанка из шерсти чёрный
joom.com
$85.14
Tamiya Scale Limited Product Японская армия Kawasaki Hien Type I Ding Kurogane Shiki Set Пластиковая модель 25203 Литье Цвет 1/48 и
joom.com
$60.06
Багажник Евродеталь аэро c замком на рейлинги Mitsubishi Space Wagon 1984- Black, Черный, OZPTSRD653
goods.ru
$14.57
Simulation RC Helicopter 3 Channesl Mini Remote Control Dragonfly Aircraft Flash Colorful LED Light-Up Flying Toy kids gifts, Red
dhgate.com
$4.91
Hot Sale Bamboo Luxury Fountain Pen Ink 0.5mm Brand For Business Gifts Decoration Writing Office Ballpoint Pen Stationery 8702
aliexpress.com














